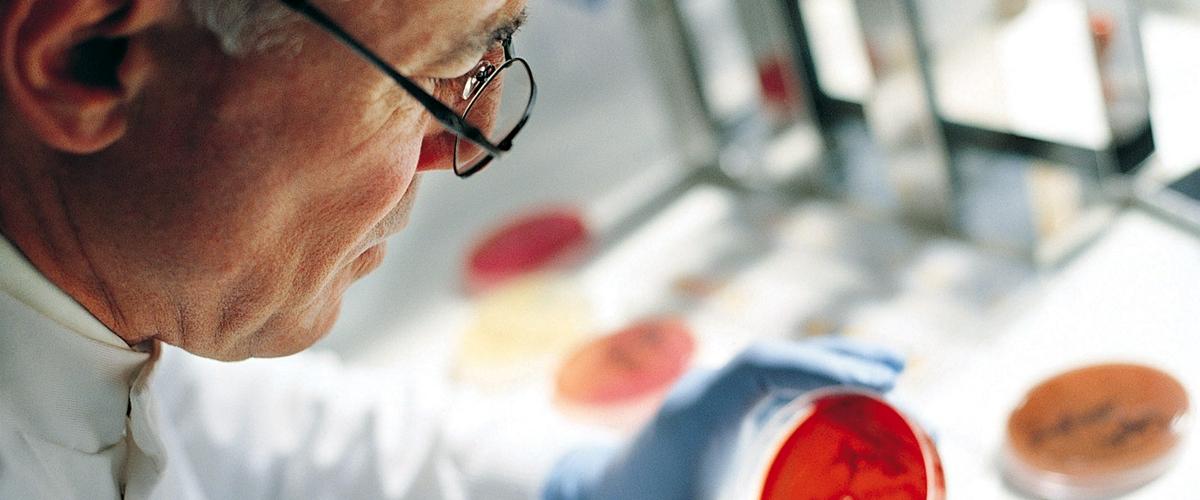
TODO:

Ученые из Университета Томаса Джефферсона доказывают, что ген gasdermin E может играть важную роль для контроля роста раковых опухолей. Кроме того, он может стать индикатором агрессивности рака, считают авторы.
Во многих случаях колоректального рака, опухоли желудка или молочной железы экспрессия gasdermin E намного ниже, чем в здоровых тканях. Ученые пока не могут объяснить, с чем это связано, однако более ранние исследования указывают, что этот ген участвует в запрограммированной гибели клеток.
Gasdermin E расщепляется ферментом caspase-3. Оказалось, что в момент расщепления он образует отверстия в клеточной мембране и мембране органелл. Это способствует высвобождению белков, которые завершают последние фазы запрограммированной клеточной гибели.
Удалив ген из злокачественных клеток, команда обнаружила, что без него они размножались примерно в два раза быстрее.
Клетки быстрее формировали опухоли, которые приводили к смерти мышей. Раковые клетки с gasdermin E росли медленнее и были намного более уязвимыми, уточняют исследователи.
Помимо потенциала в качестве новой терапевтической мишени, авторы считают, что ген может стать эффективным биомаркером для прогнозирования агрессивности опухоли. В будущем это поможет применять более эффективные стратегии лечения для каждого конкретного случая.
Авторы пока не могут назвать все типы опухолей, которые можно было бы контролировать с помощью gasdermin E. Этот вопрос будет изучаться в дальнейших исследованиях.
Недавно ученые из Великобритании выявили гены, которые важны для выживания 30 видов рака. Новая генетическая «карта» поможет в разработке противоопухолевых лекарств.